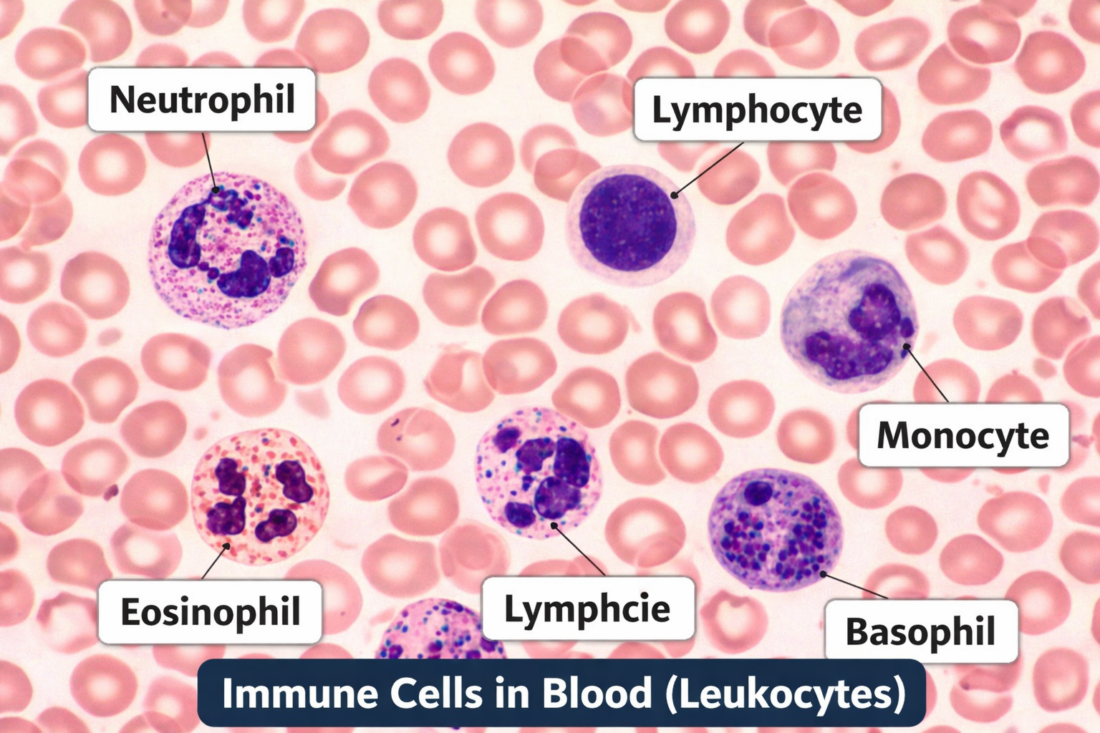

Vloga mišic, timusa in imunskega sistema pri zdravem staranju
Povzetek.
Zakaj nekateri ljudje tudi v poznih letih ostajajo vitalni, gibljivi in odporni proti boleznim, medtem ko se drugi že zgodaj soočajo z upadom moči in pogostimi okužbami? Odgovor se skriva globlje, kot si večina predstavlja – v povezavi med telesno vadbo, skeletnimi mišicami, timusom (priželjcem) in imunskim sistemom..
Sodobna znanost potrjuje, da redna telesna dejavnost ne vpliva le na mišično maso in moč, temveč tudi na imunsko mladost, vključno z delovanjem timusa tudi v odrasli dobi. Razumevanje teh mehanizmov nam daje v roke eno najmočnejših orodij za dolgo, zdravo in aktivno starost – gibanje.
1.Telesna vadba in skeletne mišice
slika: skeletne mišice med vadbo
S staranjem naravno izgubljamo mišično maso in moč – pojav, znan kot sarkopenija. Začne se že po 30. letu, po 60. letu pa se proces izrazito pospeši. Brez ustrezne telesne dejavnosti to vodi v slabšo presnovo, večje tveganje za padce in izgubo samostojnosti.
Dobra novica?
Raziskave jasno kažejo, da lahko redna vadba, zlasti:
- vadba za moč
- vzdržljivostna vadba
- kombinacija obeh
ta upad upočasni ali celo delno obrne, tudi v pozni starosti.
Zakaj so mišice tako pomembne?
- več mišične mase = boljša presnova
- močnejše mišice = manj padcev in poškodb
- aktivne mišice izločajo miokine, ki delujejo protivnetno in krepijo imunski sistem
Danes vemo, da skeletne mišice niso le “motor gibanja”, temveč pomemben endokrini organ, ki aktivno komunicira z imunskim sistemom.
2. Timus – spregledan organ imunskega staranja
slika

Timus (priželjc) je majhen organ v zgornjem delu prsnega koša, ključnega pomena za razvoj T-limfocitov – celic, ki usmerjajo imunski odziv in uničujejo okužene ali rakave celice.
Res je, da timus:
- doseže največjo aktivnost v otroštvu
- s starostjo postopno propada (involucija timusa)
Dolgo je veljalo, da v odrasli dobi skoraj nima več funkcije. A novejše raziskave kažejo drugačno sliko:
- timus tudi v odraslosti še vedno proizvaja nove T-celice
- telesna aktivnost lahko upočasni involucijo timusa
- fizično aktivni posamezniki imajo večjo raznolikost T-celic, kar je ključno za obrambo pred novimi patogeni
Z drugimi besedami: življenjski slog vpliva na to, kako “mlad” ostane naš imunski sistem.
3. Gibanje in imunski sistem
Imunske celice v krvnem obtoku
Neutrophil → Nevtrofilec,Lymphocyte → Limfocit,Monocyte → Monocit,Eosinophil → Eozinofilec
Basophil → Bazofilec
Redna telesna vadba ima izjemno močan vpliv na delovanje imunskega sistema. Med vadbo se poveča pretok krvi, kar omogoči učinkovitejše “patruljiranje” imunskih celic po telesu.
Vadba:
- poveča cirkulacijo T-celic in NK-celic
- spodbuja izločanje protivnetnih citokinov
- zmanjšuje kronično nizkointenzivno vnetje, enega ključnih mehanizmov staranja
Kaj kažejo raziskave?
- aktivni posamezniki imajo manj okužb
- boljši odziv na cepljenje
- počasnejši razvoj imunosenescence
- bolj učinkovit odziv na virusne okužbe
Mit: intenzivna vadba oslabi imunski sistem


slika: “open window theory”, vir slik:researchgate.net
Stara teorija t. i. open window je trdila, da intenzivna vadba začasno oslabi imunski sistem. Danes vemo, da:
- zmerna in redna vadba imunski sistem krepi
- tudi intenzivna vadba ni škodljiva, če ji sledi ustrezen počitek
- spremembe po vadbi pomenijo prerazporeditev imunskih celic, ne njihove oslabitve
4. Skupna slika: vadba, starost, timus in imunski sistem
Sodobne študije vse bolj jasno kažejo, da telesna vadba:
- spodbuja nastajanje novih T-celic
- izboljšuje imunski nadzor
- zmanjšuje tveganje za okužbe, vnetja in kronične bolezni
- upočasnjuje imunološko staranje
- izboljšuje izid okužb, povezanih s staranjem (tudi pri COVID-19)
Telesna aktivnost je tako eden najmočnejših naravnih imunomodulatorjev, ki jih imamo na voljo – brez recepta in brez stranskih učinkov.
5.Vadbeni okvir za zdravo staranje, mišice in imunski sistem


Vir slik: Unsplash (avtorji: Jonathan Borba, CDC, Ben White)
Razumevanje povezave med telesno vadbo, mišicami, timusom in imunskim sistemom je pomembno – še pomembneje pa je, kako to znanje uporabiti v vsakdanjem življenju. Dobra novica je, da za podporo imunskemu sistemu in ohranjanje vitalnosti ne potrebujemo ekstremnih treningov.
1. Vadba za moč (2–3× tedensko)
Zakaj?
Vadba za moč ohranja mišično maso, spodbuja izločanje miokinov in posredno podpira imunski sistem ter delovanje timusa.
Primeri vaj:
- vstajanje s stola
- počepi ob opori
- potisk v steno ali s prsnim košem
- veslanje z elastiko
- nošenje lažjih bremen
⏱️ 20–30 minut
🎯 Intenzivnost: občutek, da bi zmogli še 1–2 ponovitvi
📌 Pomembno: pravilna izvedba je pomembnejša od teže
2. Aerobna vadba (večino dni v tednu)



Vir slik: Unsplash (avtorji: CDC, Markus Spiske, Christian Buehner)
Zakaj?
Aerobna vadba izboljšuje cirkulacijo imunskih celic, zmanjšuje kronično vnetje in podpira srčno-žilni sistem.
Primeri:
- hitra hoja
- nordijska hoja
- kolesarjenje
- plavanje
⏱️ Približno 30 minut
🎯 Intenzivnost: lahko govoriš, a ne poješ
3. Ravnotežje in koordinacija (vsak dan, kratek čas)



Vir slik: Unsplash (avtorji: CDC, Ryan Franco, Jacek Dylag)
Zakaj?
Vadba ravnotežja neposredno zmanjšuje tveganje za padce, ki so eden glavnih vzrokov izgube samostojnosti v starosti.
Primeri:
- stoja na eni nogi ob opori
- hoja po ravni črti
- počasni nadzorovani gibi (tai chi, nežna joga)
⏱️ 5–10 minut dnevno
📌 Bolje malo vsak dan kot veliko enkrat tedensko
4. Regeneracija – temelj imunskega zdravja
Vadba krepi imunski sistem le, če jo spremlja:
- dovolj spanja
- dnevi z nižjo intenzivnostjo
- poslušanje telesa
Pri starejših odraslih preutrujenost lahko oslabi imunski odziv, medtem ko premišljena, redna vadba deluje zaščitno.
6. Razlika v vadbi med »60+« in »70+«
60+ let
Cilj:
- ohranjanje mišic
- preprečevanje sarkopenije
- dobra toleranca vadbe
Značilnosti:
- večja vadbena frekvenca
- še vedno možna progresija
- več vadbe za moč
Primer:
- 2–3× tedensko moč
- 30–45 min hoje ali kolesa
- zahtevnejše ravnotežje
70+ let
Cilj:
- samostojnost
- preprečevanje padcev
- ohranjanje imunskega odziva
Značilnosti:
- več poudarka na varnosti
- manj intenzivnosti
- več krajših enot
Primer:
- 1–2× tedensko moč
- vsakodnevna hoja (lahko krajša)
- ravnotežje vsak dan
- več počitka
70+
Cilj:
- samostojnost
- preprečevanje padcev
- ohranjanje imunskega odziva
Značilnosti:
- več poudarka na varnosti
- manj intenzivnosti
- več krajših enot
Primer:
- 1–2× tedensko moč
- vsakodnevna hoja (lahko krajša)
- ravnotežje vsak dan
- več počitka
👉 Razlika NI v tem, ali vadijo –
ampak kako, kako pogosto in kako močno.
Ključno sporočilo
Za podporo mišicam, timusu in imunskemu sistemu:
- bodite redno telesno dejavni
- kombinirajte moč, vzdržljivost in ravnotežje
- prilagodite intenzivnost svoji trenutni zmožnosti
👉 Telo se na gibanje odziva v vseh starostih – razlika je le v tem, kako pametno ga uporabljamo.
Zaključek
Povezava med telesno vadbo, mišicami, timusom in imunskim sistemom nam jasno sporoča:
aktivnost ni luksuz – je biološka potreba.
Redno gibanje:
- ohranja mišično maso in moč
- podpira delovanje timusa
- krepi imunski sistem
- zmanjšuje kronično vnetje
- izboljšuje kakovost življenja v starosti
Začeti ni treba z ekstremi. Že:
- 30 minut hoje na dan
- nekaj vaj za moč 2–3× tedensko
- več gibanja v vsakdanjem življenju lahko naredi ogromno razliko.
👉 Nikoli ni prepozno. Telo se na gibanje odziva v vseh starostih.
Kako v praksi vzdržujem kardiološko pripravljenost, si lahko ogledate v mojih kolesarskih in turnosmučarskih zapisih
Ključne reference (zelo dobre):
- Goronzy JJ, Weyand CM. Mechanisms underlying T cell aging. Nat Rev Immunol, 2019.
- Duggal NA et al. Can physical activity modulate immunosenescence? Front Immunol, 2018.
- Simpson RJ, Campbell JP. Exercise and the aging immune system. Aging Res Rev, 2020.
- Pedersen BK, Febbraio MA. Muscles as endocrine organs. Nat Rev Endocrinol, 2012.
Dopolnilne reference:
- Palmer DB. The effect of age on thymic function. Front Immunol, 2013.
- Nieman DC, Wentz LM. The compelling link between physical activity and immune defense. J Sport Health Sci, 2019.
- Turner JE. Is immunosenescence influenced by lifestyle? Biogerontology, 2016.
- Got immunity? Thank your thymus. Quick, point to your thymus gland.
- Train your T cells: How skeletal muscles and T cells keep each other fit during aging
- Exercise Promotes Tissue Regeneration: Mechanisms Involved and Therapeutic Scope
Opomba o nastanku vsebine: Ta prispevek je bil pripravljen na podlagi osebnega zanimanja za tematiko zdravja in dolgoživosti ter napisan s pomočjo umetne inteligence (UI), ki je pomagala pri strukturiranju strokovnih podatkov v berljivo in pregledno obliko.


Dodaj odgovor